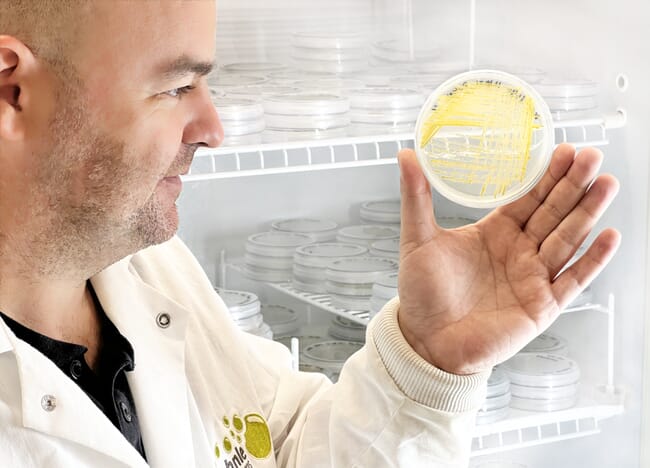
A man with a petri dish.

Left to right: Bob Schurr, Gordon Wallace, Konrad Aufferman, Claude Kaplan and Heidi Kuenhle
Astaxanthin, a powerful antioxidant and the pigment responsible for the characteristic colour of salmon, trout and several species of crustacean, is one of the most valuable additives in aquafeeds. But the source of that pigment – whether synthetic or natural – is becoming an increasingly strategic decision in a marketplace shaped by sustainability claims, consumer expectations and tightening margins.
Just over five years after they turned their focus onto harnessing fermentation to produce natural astaxanthin, following multiple scale-ups and two major funding rounds, Kaplan believes that KAS is closer than any company has ever been to making natural astaxanthin cost-competitive with synthetic alternatives.
“A lot of companies have tried to do grow Haematococcus – the microalgae which produces the most highly active astaxanthin and at the highest concentration – using fermentation, but it’s really, really difficult,” Kaplan explains. “Most tried it and gave up. Our team didn’t. They kept going because they believed it could be done – and now we’re starting to see the results.”
Kaplan’s arrival at KAS in 2021 felt almost tailor-made. With a background that included plant science, food systems, aquaculture, technology commercialisation, IP, marketing and sales, he saw a rare opportunity to combine his broad range of experience.
“It was the perfect combination of everything I’d done before – from science, to commercialisation, to building markets,” he says. “I realised this was a technology that, if it worked, could genuinely shift an entire industry.”
When he joined, the core team numbered only three people. Today it is eight-strong, with further recruitment ongoing as they seek to address the technical and commercial challenges that scaling fermentation-based astaxanthin demands.
Why natural astaxanthin?
Globally, natural astaxanthin is still only used by a small slice of the salmon sector – roughly 10 percent, by Kaplan’s estimate – although some regions or sectors are more reliant on it than others.
“The entire Scottish and organic salmon industries use natural astaxanthin,” he says. “Natural is perceived as higher quality, and there’s a strong story behind it. Farmers need something with the performance and marketability of natural astaxanthin, but with the affordability of synthetic pigment.”
KAS also has its eye firmly on China. Demand for natural red pigments in fish is rising – not just for salmonids, but also for local fish and crustacean species, as red is viewed as being a lucky colour, so pigmentation can mean the difference between premium and commodity pricing.
“China’s natural astaxanthin market is growing very fast,” Kaplan says. “It won’t all be salmon; a lot of it is domestic species. The appetite is there.”
The stumbling block is price. Natural astaxanthin produced via algae grown in ponds or photobioreactors typically costs around 10 times more than the synthetic version, while that produced by bacterial fermentation is roughly four to five times more costly than synthetic.
“It is well documented that astaxanthin from algae has the highest antioxidant and anti-inflammatory properties and that’s why it is the only astaxanthin used in human nutritional supplements. But currently the price premium is just too high for fish farmers. If we can get natural astaxanthin much closer to the cost of synthetic, the whole market changes overnight,” Kaplan says. “Farmers want natural – they just can’t afford it at current prices.”

© Gordon Wallace
The art of dark fermentation
Most algal astaxanthin producers rely on light. Whether in outdoor ponds or sealed photobioreactors, microalgae grow by absorbing the energy from light. This dramatically limits how quickly they can grow, how dense the culture can be and ultimately drives up the time and cost to produce astaxanthin.
KAS, on the other hand, has developed a method known as dark fermentation, which uses the identical microalgae species but produces astaxanthin without light, meaning it can be grown in standard stainless-steel fermentation tanks – the same technology used for brewing beer or producing precision-fermented proteins.
According to Kaplan the advantages are substantial, not least that the algae are ready to harvest after only four days, rather than six weeks, and are produced in orders of magnitude more biomass per litre – while using less energy, water and land.
“You can make a huge amount of biomass in a very small footprint,” Kaplan notes. “That’s what makes fermentation so attractive. But it’s also what makes it so technically challenging. The biology has to be perfect.”
KAS’s team in Hawaii spent years selecting the algal strains and refining the process. Several companies had attempted similar concepts but failed to maintain high astaxanthin yields under fermentation conditions.
“It was persistence, basically,” Kaplan says. “The science was solid, but the optimisation was required many incremental steps of process and strain optimisation. The team kept continuously improving, while others walked away when they didn’t see quicker results – and that’s why we’re now getting results.”
Scaling
When Kaplan joined, KAS was working in their own lab with a 100-litre fermentation vessel. The ambition was to ramp up to 6,000-litre batches – the start of the industrial production scale – with their manufacturing partner in France, Biorea, within six months. It ended up taking several years.
“Everyone assumed scaling would be straightforward. But when it comes to fermentation, scaling is never straightforward,” he reflects. “It’s taken an enormous amount of work, but we’re now running at 6,000 litres and learning from every run.”
The company has consistently achieved improvements in its strain of algae, boosting yields and stability. But Kaplan admits that not all of the performance metrics have been hit yet.
“We’ve solved most of the big challenges, but we’re not quite where we need to be,” he says. “That’s normal – every strain in fermentation-based industries goes through cycles of improvement. We’re progressing faster than ever.”
Another link that’s missing is the need to conduct more extensive aquaculture trials.
Early small-scale trials in shrimp, salmon and trout were “using trial material” in Kaplan’s words, because the product wasn’t available at industrial scale. In the future, with material from 6,000-litre batches, KAS plans to run additional trials with several key customers.
“Farmers want proof. And soon we hope to be in a position to generate the quantities needed to give them that proof,” he says.
Combining with Corbion
In 2025, KAS entered a joint development agreement with Corbion, a global fermentation leader, which was already involved in aquafeeds having scaled up an algae-derived omega-3 company to launch AlgaPrime DHA.
“They know exactly how to take an algae fermentation process, improve it and reduce the cost to industrial levels. That’s invaluable,” notes Kaplan.
The partnership gives KAS a number of advantages, including access to Corbion’s facilities in San Francisco, as well as access to world class analytical capabilities and process optimisation at industrial scale. It also paved the way for the recruitment of a new CTO, Konrad Aufferman, a highly experienced fermentation engineer who had been on the leadership of two of the biggest names in the cultured meat space, Meati and Upside Foods.
Funding and the path to a commercial demonstrator
Following a $3.2 million AquaSpark investment in 2021 and a $3 million S2G investment in 2024, KAS is now raising additional capital to build a commerical demonstrator facility – a critical step alongside CMO production – to fully optimise the technology for low-cost high-value production essential to hit the volumes and price point for aquaculture, as well as being able to produce larger batches for field trials.
“We’re raising for the next phase – the commercial demonstrator, built in partnership with Corbion,” Kaplan says. “Once that’s in place, we’ll be able to supply customers with larger amount of representative material, essential for proving out the technology in field trials. That’s when you see real market adoption.”
If KAS succeeds, natural astaxanthin could become accessible to a far broader segment of the aquaculture industry. Cost-competitiveness would allow farmers to differentiate their products with natural pigments without incurring heavy premiums, as well as benefitting from the many health and nutritional benefits that natural algal astaxanthin has been shown to offer.
“Farmers are highly supportive of natural astaxanthin – they just need consistency and affordability,” Kaplan notes. “If we provide that, adoption will jump very quickly.”
“This has been years of effort from an incredibly dedicated team,” he adds. “We’re getting closer every month. And if we do this right, natural astaxanthin won’t be a niche product anymore – it’ll be the standard.”
*KAS is part of Hatch Blue's investment portfolio, but The Fish Site retains editorial independence.





